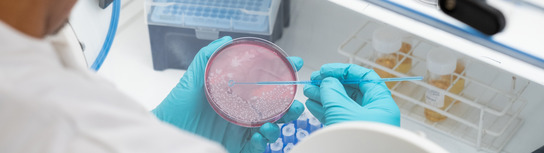
Scientist

|
Welcome to your June 2025 edition of MHRA News.
The essential industry newsletter where we update you on our most recent activities.
To keep hearing from us with future editions, register here.
 We continue to report positively on our performance against agreed key performance indicators in MHRA’s statutory functions: licence applications for innovative and established medicines, variations to licences, and manufacturing and distribution authorisations. Average timescales for statutory functions are reducing in most areas.
Our priority is to maintain performance to predictable and statutory timeframes. We will continue to publish monthly updates providing applicants with transparent information on expected timescales.
Our data for May 2025 show that 100% of clinical trials and investigations applications continue to be handled within statutory timescales. The latest data show an average time for Combined Review determination (including questions raised) of 40 days in April.
100% of national licence applications continue to be assessed within our statutory timescales of 210 days: with an average timescale of 176 days in May.
More resources are now available to help clear scientific advice requests and we expect further signs of positive impact to be reported in our data for future months. We will sustain this effort and by Autumn 2025, we will have restored performance in scientific advice to expected timescales, and will provide more information over the coming months as part of our wider work to further develop and enhance our scientific advice services
 Our senior leaders have set out how the MHRA will capitalise on its emerging strengths – summarised by our Chief Executive Lawrence Tallon as “fast, expert and open” – by setting out a clear and focused strategic direction. These strategic aims are set to help cement the UK as a global leader in risk-proportionate regulation and are focused on patient and public safety, accelerated access and 10X innovation.
We have published our Business Plan for 2025/26, reaffirming our commitment to keeping patients safe and enabling access to high quality and effective medical products through innovation across the UK. Our Business Plan includes objectives that will strengthen patient safety, implement an agile and risk-proportionate regulatory environment that enables growth, and embed the changes needed to continue maintaining consistent performance and efficient delivery of core services within predictable timeframes. |
|
 |
Forwarded this email by a colleague?
We have announced our new digital hub in Leeds, marking a significant step in the agency’s long-term commitment to advancing innovation and strengthening its presence across the UK. Leeds was selected due to its expertise in digital health and strong academic base. The digital hub forms part of our broader strategy to enhance regulatory agility, strengthen digital capabilities, and deliver better outcomes for patients, the public and industry. It will also enable closer collaboration with digital health networks, NHS organisations, and leading academic institutions nationwide.
|
A strong focus on clinical research is indicated to be part of the forthcoming 10 Year Health Plan as NIHR launches a UK-wide recruitment drive for clinical trials. This month we supported Be Part of Research - the biggest ever health research campaign to get as many people involved in research as possible. The activity will supported by changes that allow the public to register for trials through the NHS App. Also this month we published new guidance on our clinical trials hub, alongside the HRA ‘s Guidance on changes to the clinical trials regulations, to support sponsors in preparation for the updated clinical trials regulations, which come into force on 28 April 2026.
 You have until 14 July to give your views in the consultation on our draft guideline to support clinical trials sponsors who are considering using external control arms based on real-world data, to support regulatory decisions. This use of real-world data from sources such as electronic health records, disease and patient registries and patient-reported outcomes data, has the potential to help accelerate the approval of treatments, especially when randomised controlled trials may not be ethical or feasible. We are interested in getting a wide range of responses from people interested in clinical trials.
This week we opened our AI Airlock Call for Applications, for only the second time. We are looking for three to four innovative AI as a medical device products to join our AI Airlock programme. To be successful, the medical devices must have the potential to deliver significant benefits to patients and the NHS, present a new treatment approach and offer a regulatory challenge ready to be tested. The AI Airlock is a first-of-its-kind regulatory testing ground where companies can work directly with regulators to safely test new AI-powered medical devices and explore how to bring them to patients faster, through streamlined regulations.
|
 On 24 June 2025, the UK become the first country in the world to join a new global network of health regulators focused on the safe, effective use of artificial intelligence (AI) in healthcare. By joining the HealthAI Global Regulatory Network as a founding ‘pioneer’ country, we will work with regulators around the world to share early warnings on safety, monitor how AI tools perform in practice, and shape international standards together – helping make AI in healthcare safer and more effective for patients around the world.
This is the question addressed by Marinos Ioannides, our Head of Software and AI Medical Devices, in this month’s Med Tech Regulations blog. Marinos gives at update on work from two of the Centres of Excellence for Regulatory Science and Innovation (CERSIs), and gives his perspective on initiatives from Software and AI and wider Innovative Devices team at the MHRA.
June saw the first major overhaul of medical device regulation, with the new Post-market Surveillance (PMS) regulations taking effect on 16 June. The updated regulations require medical device manufacturers to proactively monitor the safety and performance of their products. The reforms apply to all UKCA and CE-marked devices placed on the GB market after 16 June and are an important milestone in our work to build a modern, responsive regulatory system for medical devices which puts patients first while also supporting innovation in life science and medical technologies. New forms and guidance have been published to help manufacturers understand and comply with the new reporting requirements on the Manufacturers online reporting environment (MORE).
We have published new guidance to help industry prepare for the UK’s new decentralised manufacturing framework. On 23 July, the UK will become the first country in the world to introduce a tailored framework to support the manufacture of innovative medicines made at or near the point of patient care, such as personalised cancer treatments and rapid-response vaccines. The new guidance explains how existing regulatory requirements will apply in decentralised settings and how this differs from conventional manufacturing.
 We have published guidance to help researchers and companies develop bacteriophage-based medicines that meet UK safety, quality and efficacy standards. Our publication sets out how existing UK and international regulatory frameworks apply to phage treatments – from early research through to use in patients. The guidance was developed with input from the Phage Innovation Network, a cross-sector group supported by Innovate UK, and from industry, clinicians and academic researchers.
We have published an information update on using the electronic Common Technical Document (eCTD) in product licence submissions, related to historical sequences. The MHRA check that eCTD submissions are technically valid using the Lorenz Docubridge validation tool which strictly aligns validation against the International Council for Harmonisation of Technical Requirements for Pharmaceuticals for Human Use (ICH) international standards and eCTD 3.2 regional requirements.
The pioneering Yellow Card Biobank, in partnership with Genomics England, will start investigating whether the risk of acute pancreatitis (inflamed pancreas) from GLP-1 injections for weight loss and type 2 diabetes may be influenced by an individual’s genes. The Yellow Card Biobank aims to help understand how a patient’s genetic makeup can impact the safety of their medicines and forms part of a long-term vision for more personalised medicine approaches.
 We have seized almost eight million doses of illegal medicines as part of an annual global coordinated operation to tackle the illegal online sale of medicines and medical devices. Operation Pangea, coordinated by Interpol and involving around 90 countries, is the world’s largest initiative of its kind. It brings together health regulators, customs authorities, law enforcement agencies, and private sector partners to tackle the threat posed by criminal networks operating in the global supply of illegal medicines. As part of the operation, we also coordinated several arrest operations, denied gangs access to almost £1.4m in criminal profits, and removed 367 websites and social media accounts offering medical products to the public illegally.
You can write to us, email us or call us to get in touch with the MHRA. Find out how near the bottom of our homepage.
For any comments and feedback on this newsletter, please email: info@mhra.gov.uk.
To keep hearing from us with future editions, register here.
Stay connected
|